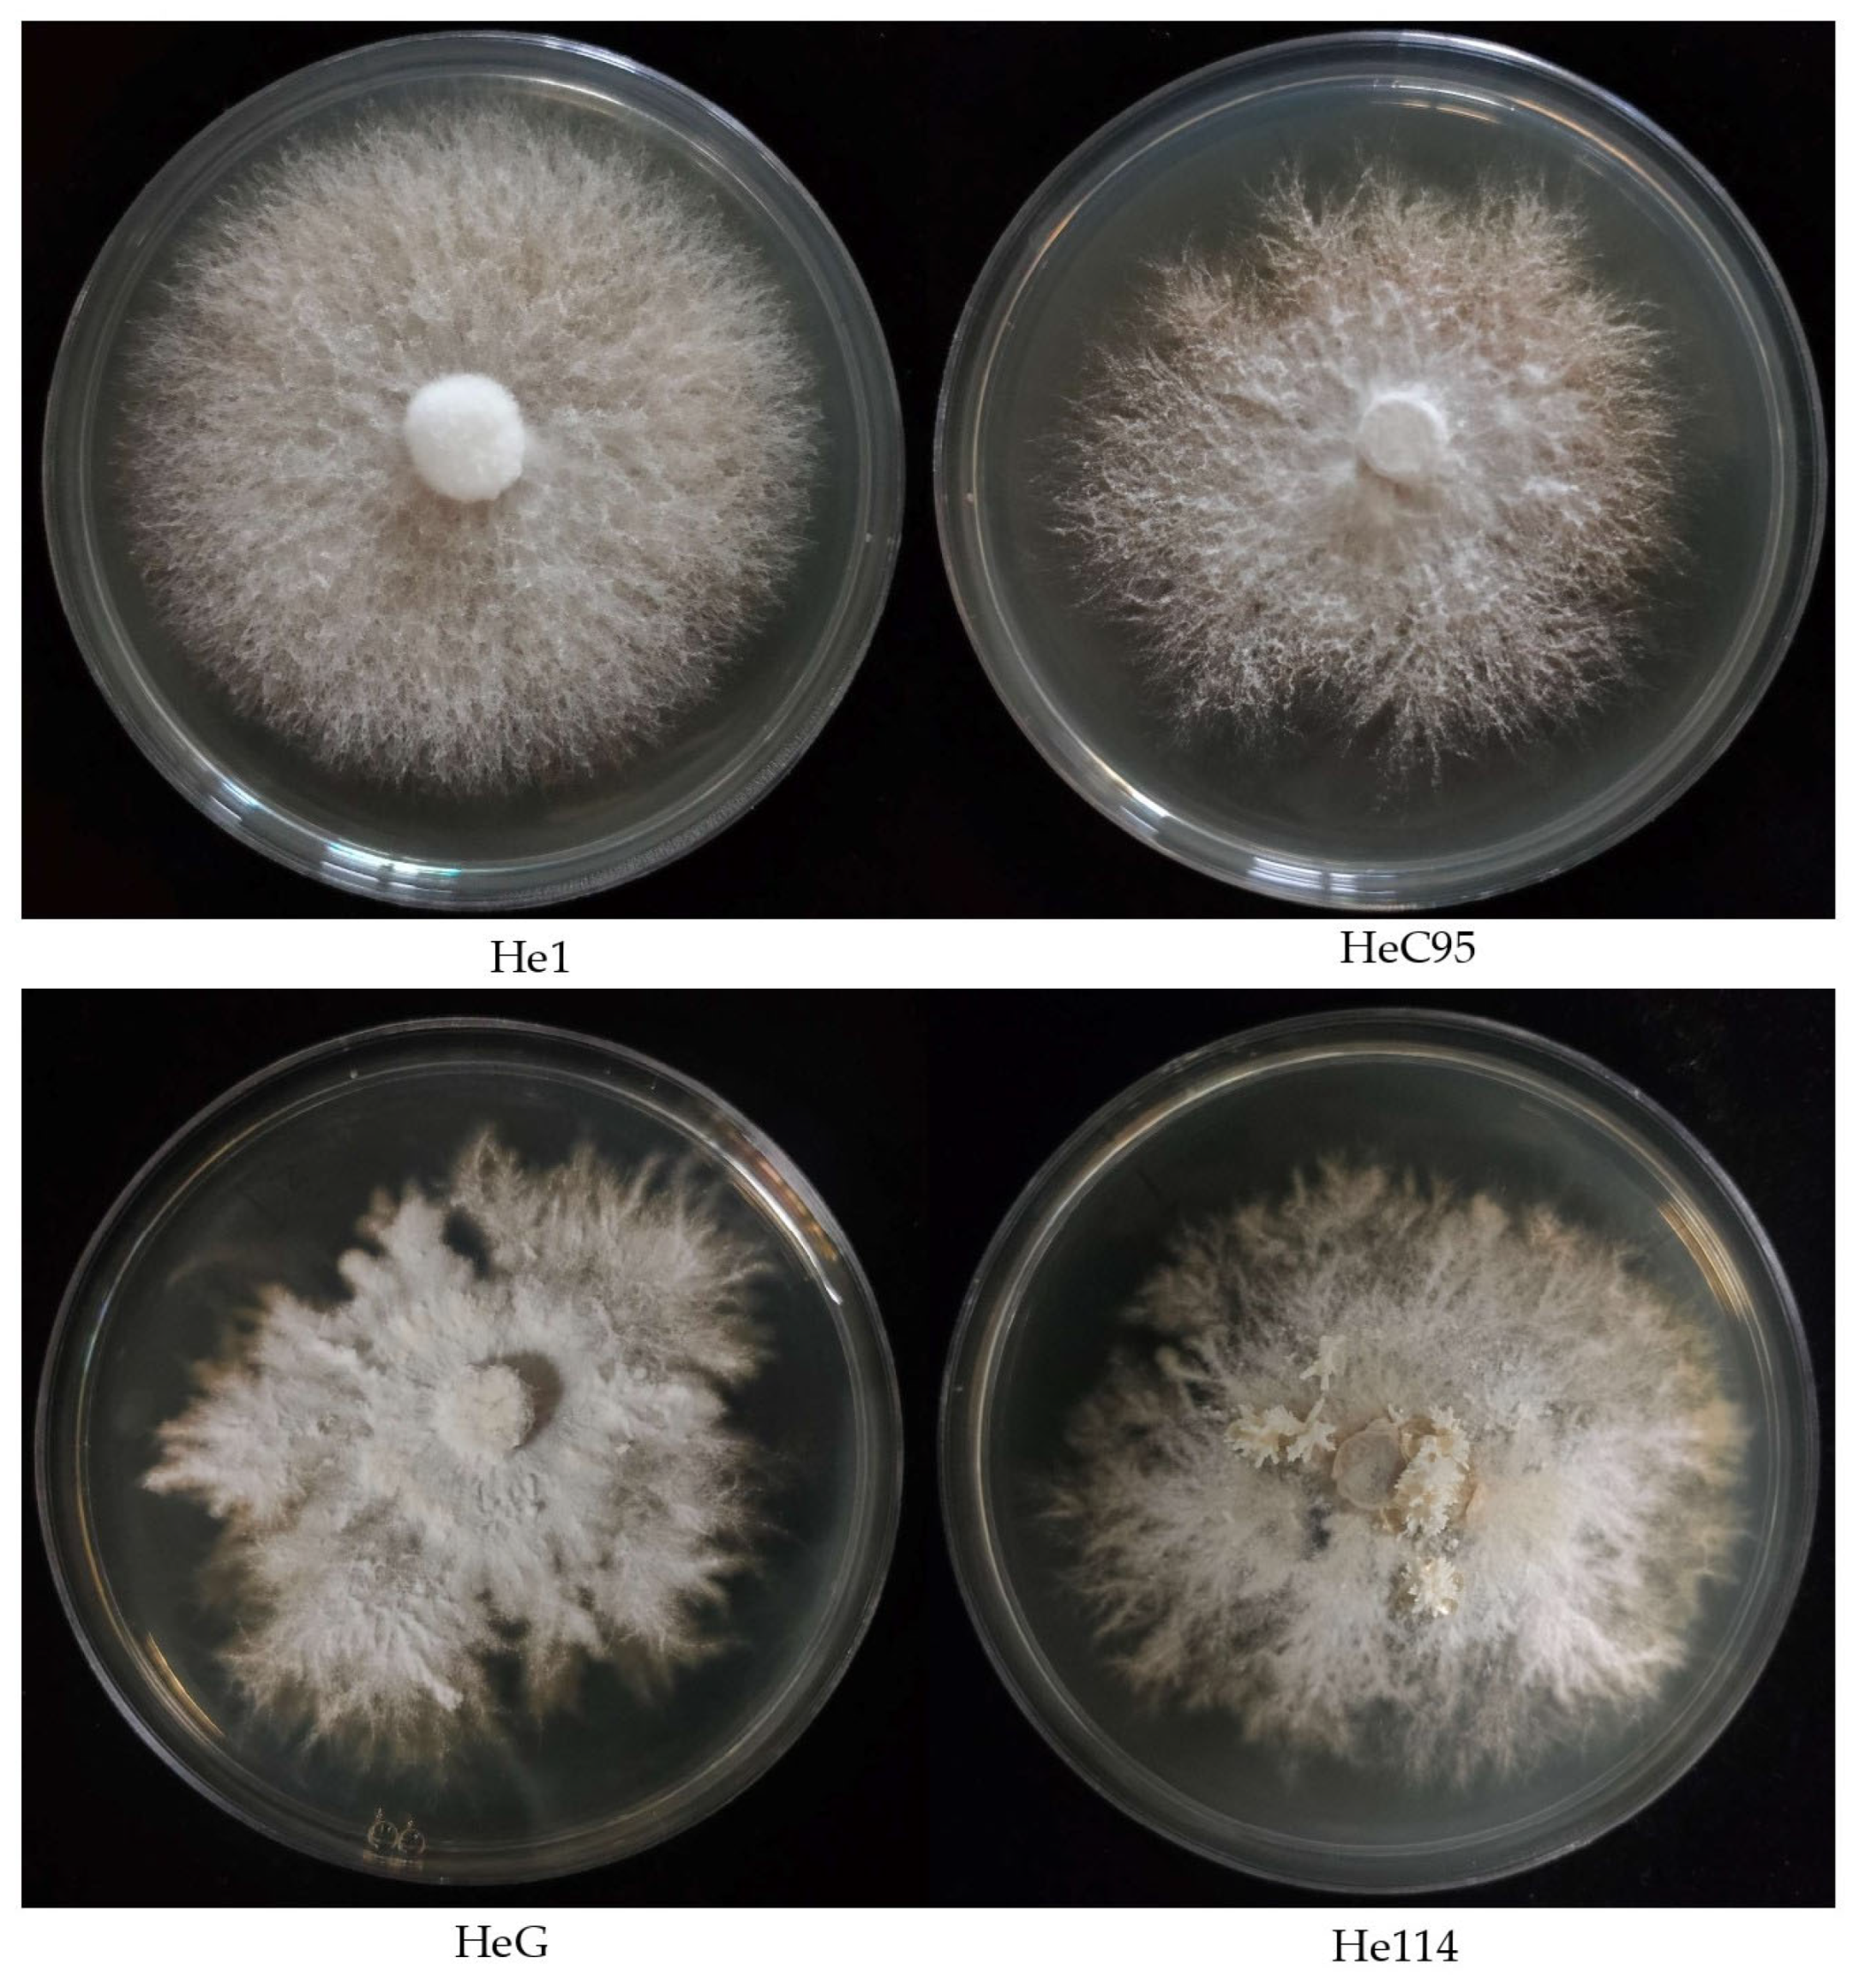
Foods 13 01649 g003

Isolation and Evaluation of Erinacine A Contents in Mycelia of Hericium erinaceus Strains
Abstract
1. Introduction
2. Materials and Methods
2.1. H. erinaceus Strains and Mycelial Growth
2.2. Preparation of Erinacine A Crude Extract
2.3. Determining the Two-Phase Solvent System
2.4. Preparation of Two-Phase Solvent System and Sample Solution
2.5. HSCCC Isolation
2.6. Quantification of Erinacine A Content in Different Hericium Strains
2.7. Statistical Analysis
3. Results and Discussion
3.1. Selection of the Solvent System
3.2. Separation by HSCCC and Identification of Erinacine A
3.3. Mycelial Growth of Hericium Strains
3.4. Erinacine A in the Mycelia of Hericium Strains
3.5. Identification of Superior Strains
4. Conclusions
Supplementary Materials
Author Contributions
Funding
Institutional Review Board Statement
Informed Consent Statement
Data Availability Statement
Conflicts of Interest
References
- Grimm, D.; Wösten, H.A.B. Mushroom cultivation in the circular economy. Appl. Microbiol. Biotechnol. 2018, 102, 7795–7803. [Google Scholar] [CrossRef] [PubMed]
- Zhang, L.; Gong, W.B.; Li, C.; Shen, N.; Gui, Y.; Bian, Y.B.; Kwan, H.S.; Cheung, M.K.; Xiao, Y. RNA-Seq-based high-resolution linkage map reveals the genetic architecture of fruiting body development in shiitake mushroom, Lentinula edodes. Comput. Struct. Biotechnol. J. 2021, 19, 1641–1653. [Google Scholar] [CrossRef]
- Chang, S.; Buswell, J. Medicinal mushrooms: Past, present and future. Adv. Biochem. Eng./Biotechnol. 2023, 184, 1–27. [Google Scholar] [PubMed]
- Okuda, Y. Sustainability perspectives for future continuity of mushroom production: The bright and dark sides. Front. Sustain. Food Syst. 2022, 6, 1026508. [Google Scholar] [CrossRef]
- Holt, R.R.; Munafo, J.P., Jr.; Salmen, J.; Keen, C.L.; Mistry, B.S.; Whiteley, J.M.; Schmitz, H.H. Mycelium: A nutrient-dense food to help address world hunger, promote health, and support a regenerative food system. J. Agric. Food Chem. 2024, 72, 2697–2707. [Google Scholar] [CrossRef]
- He, X.; Wang, X.; Fang, J.; Chang, Y.; Ning, N.; Guo, H.; Huang, L.; Huang, X.; Zhao, Z. Structures, biological activities, and industrial applications of the polysaccharides from Hericium erinaceus (Lion’s Mane) mushroom: A review. Int. J. Biol. Macromol. 2017, 97, 228–237. [Google Scholar] [CrossRef] [PubMed]
- Wang, X.Y.; Zhang, D.D.; Yin, J.Y.; Nie, S.P.; Xie, M.Y. Recent developments in Hericium erinaceus polysaccharides: Extraction, purification, structural characteristics and biological activities. Crit. Rev. Food Sci. Nutr. 2019, 59 (Suppl. S1), S96–S115. [Google Scholar] [CrossRef] [PubMed]
- Cheng, P.Y.; Liao, H.Y.; Kuo, C.H.; Liu, Y.C. Enhanced erinacine A production by Hericium erinaceus using solid-state cultivation. Fermentation 2021, 7, 182. [Google Scholar] [CrossRef]
- Kobayashi, S.; Tamura, T.; Koshishiba, M.; Yasumoto, T.; Shimizu, S.; Kintaka, T.; Nagai, K. Total synthesis, structure revision, and neuroprotective effect of hericenones C-H and their derivatives. J. Org. Chem. 2021, 86, 2602–2620. [Google Scholar] [CrossRef] [PubMed]
- Li, I.C.; Lee, L.Y.; Tzeng, T.T.; Chen, W.P.; Chen, Y.P.; Shiao, Y.J.; Chen, C.C. Neurohealth properties of Hericium erinaceus mycelia enriched with erinacines. Behav. Neurol. 2018, 2018, 5802634. [Google Scholar] [CrossRef]
- Brandalise, F.; Roda, E.; Ratto, D.; Goppa, L.; Gargano, M.L.; Cirlincione, F.; Priori, E.C.; Venuti, M.T.; Pastorelli, E.; Savino, E.; et al. Hericium erinaceus in neurodegenerative diseases: From bench to bedside and beyond, how far from the shoreline? J. Fungi 2023, 9, 551. [Google Scholar] [CrossRef] [PubMed]
- Yanshree Yu, W.S.; Fung, M.L.; Lee, C.W.; Lim, L.W.; Wong, K.H. The monkey head mushroom and memory enhancement in Alzheimer’s disease. Cells 2022, 11, 2284. [Google Scholar] [CrossRef] [PubMed]
- Bailly, C.; Gao, J.M. Erinacine A and related cyathane diterpenoids: Molecular diversity and mechanisms underlying their neuroprotection and anticancer activities. Pharmacol. Res. 2020, 159, 104953. [Google Scholar] [CrossRef] [PubMed]
- Tzeng, T.T.; Chen, C.C.; Chen, C.C.; Tsay, H.J.; Lee, L.Y.; Chen, W.P.; Shen, C.C.; Shiao, Y.J. The cyanthin diterpenoid and sesterterpene constituents of Hericium erinaceus mycelium ameliorate Alzheimer’s disease-related pathologies in APP/PS1 transgenic mice. Int. J. Mol. Sci. 2018, 19, 598. [Google Scholar] [CrossRef] [PubMed]
- Lee, K.F.; Chen, J.H.; Teng, C.C.; Shen, C.H.; Hsieh, M.C.; Lu, C.C.; Lee, K.C.; Lee, L.Y.; Chen, W.P.; Chen, C.C.; et al. Protective effects of Hericium erinaceus mycelium and its isolated erinacine A against ischemia-injury-induced neuronal cell death via the inhibition of iNOS/p38 MAPK and nitrotyrosine. Int. J. Mol. Sci. 2014, 15, 15073–15089. [Google Scholar] [CrossRef] [PubMed]
- Lee, S.L.; Hsu, J.Y.; Chen, T.C.; Huang, C.C.; Wu, T.Y.; Chin, T.Y. Erinacine A prevents Lipopolysaccharide-mediated glial cell activation to protect dopaminergic neurons against inflammatory factor-induced cell death in vitro and in vivo. Int. J. Mol. Sci. 2022, 23, 810. [Google Scholar] [CrossRef]
- Zhang, C.C.; Cao, C.Y.; Kubo, M.; Harada, K.; Yan, X.T.; Fukuyama, Y.; Gao, J.M. Chemical constituents from Hericium erinaceus promote neuronal survival and potentiate neurite outgrowth via the TrkA/Erk1/2 pathway. Int. J. Mol. Sci. 2017, 18, 1659. [Google Scholar] [CrossRef] [PubMed]
- Rodriguez, M.N.; Lippi, S.L.P. Lion’s Mane (Hericium erinaceus) exerts anxiolytic effects in the rTg4510 Tau mouse model. Behav. Sci. 2022, 12, 235. [Google Scholar] [CrossRef] [PubMed]
- Kenmoku, H.; Sassa, T.; Kato, N. Isolation of erinacine P, a new parental metabolite of cyathane-xylosides, from Hericium erinaceum and its biomimetic conversion into erinacines A and B. Tetrahedron Lett. 2000, 41, 4389–4393. [Google Scholar] [CrossRef]
- Kawagishi, H.; Masui, A.; Tokuyama, S.; Nakamura, T. Erinacines J and K from the mycelia of Hericium erinaceum. Tetrahedron 2006, 62, 8463–8466. [Google Scholar] [CrossRef]
- Krzyczkowski, W.; Malinowska, E.; Herold, F. Erinacine A biosynthesis in submerged cultivation of Hericium erinaceum: Quantification and improved cultivation. Eng. Life Sci. 2010, 10, 446–457. [Google Scholar] [CrossRef]
- Song, H.; Lin, J.; Zhu, X.; Chen, Q. Developments in high-speed countercurrent chromatography and its applications in the separation of terpenoids and saponins. J. Sep. Sci. 2016, 39, 1574–1591. [Google Scholar] [CrossRef] [PubMed]
- Li, L.; Zhao, J.; Yang, T.; Sun, B. High-speed countercurrent chromatography as an efficient technique for large separation of plant polyphenols: A review. Food Res. Int. 2022, 153, 110956. [Google Scholar] [CrossRef] [PubMed]
- Song, G.; Du, Q. Isolation of a polysaccharide with anticancer activity from Auricularia polytricha using high-speed countercurrent chromatography with an aqueous two-phase system. J. Chromatogr. A 2010, 1217, 5930–5934. [Google Scholar] [CrossRef] [PubMed]
- Cheng, C.; Li, Y.; Xu, P.; Feng, R.; Yang, M.; Guan, S.; Guo, D. Preparative isolation of triterpenoids from Ganoderma lucidum by counter-current chromatography combined with pH-zone-refining. Food Chem. 2012, 130, 1010–1016. [Google Scholar] [CrossRef]
- He, J.; Fan, P.; Feng, S.; Shao, P.; Sun, P. Isolation and purification of two isoflavones from Hericium erinaceum mycelium by high-speed counter-current chromatography. Molecules 2018, 23, 560. [Google Scholar] [CrossRef]
- Wang, Y.; Guo, L.; Liu, C.; Zhang, Y.; Li, S. Total triterpenoid extraction from Inonotus obliquus using ionic liquids and separation of potential lactate dehydrogenase inhibitors via ultrafiltration high-speed countercurrent chromatography. Molecules 2021, 26, 2467. [Google Scholar] [CrossRef] [PubMed]
- Lu, Z.; Ji, S.; Ren, Z.; Wang, Y.; Xie, M.; Yang, Y.; Yu, Y.; Zhang, T. Study on biological characteristics, domestication and cultivation patterns of two wild strains of Hericium erinaceus. Edible Fungi China 2023, 42, 28–33,40. [Google Scholar]
- Gonkhom, D.; Luangharn, T.; Hyde, K.D.; Stadler, M.; Thongklang, N. Optimal conditions for mycelial growth of medicinal mushrooms belonging to the genus Hericium. Mycol. Prog. 2022, 21, 82. [Google Scholar] [CrossRef]
- Gong, W.B.; Liu, K.F.; Li, X.R.; Zhang, L.; Shen, N.; Bian, Y.B.; Xiao, Y. QTL mapping reveals mating type gene LeHD1 regulating mycelial growth in shiitake mushroom, Lentinula edodes. Sci. Hortic. 2022, 305, 111417. [Google Scholar] [CrossRef]
- Ito, Y. Golden rules and pitfalls in selecting optimum conditions for high-speed counter-current chromatography. J. Chromatogr. A 2005, 1065, 145–168. [Google Scholar] [CrossRef] [PubMed]
- Liang, L.L.; Zhao, X.J.; Lu, Y.; Zhu, S.H.; Tang, Q.; Zuo, M.T.; Liu, Z.Y. An efficient method for the preparative isolation and purification of alkaloids from Gelsemium by using high speed counter-current chromatography and preparative HPLC. Prep. Biochem. Biotechnol. 2024, 1–11. [Google Scholar] [CrossRef] [PubMed]
- Kawagishi, H.; Shimada, A.; Shirai, R.; Kenji, O.; Ojima, F.; Sakamoto, H.; Ishiguro, Y.; Furukawa, S. Erinacines A, B, and C, strong stimulators of nerve growth factor (NGF)-synthesis, from the mycelia of Hericium erinaceum. Tetrahedron Lett. 1994, 35, 1569–1572. [Google Scholar] [CrossRef]
- Lee, E.W.; Shizuki, K.; Hosokawa, S.; Suzuki, M.; Suganuma, H.; Inakuma, T.; Li, J.; Ohnishi-Kameyama, M.; Nagata, T.; Furukawa, S.; et al. Two novel diterpenoids, erinacines H and I from the mycelia of Hericium erinaceum. Biosci. Biotechnol. Biochem. 2000, 64, 2402–2405. [Google Scholar] [CrossRef] [PubMed]
- Hao, T.; Fan, L.; Chang, Y.; Yang, H.; He, K. Separation and biological activities of the main compounds from the bark of Myrica rubra Siebold & Zucc. Separations 2024, 11, 4. [Google Scholar]
- Rathore, H.; Prasad, S.; Kapri, M.; Tiwari, A.; Sharma, S. Medicinal importance of mushroom mycelium: Mechanisms and applications. J. Funct. Foods 2019, 56, 182–193. [Google Scholar] [CrossRef]
- Kowalski, C.H.; Cramer, R.A. If looks could kill: Fungal macroscopic morphology and virulence. PLoS Pathog. 2020, 16, e1008612. [Google Scholar] [CrossRef] [PubMed]
- Lehmann, A.; Zheng, W.; Soutschek, K.; Roy, J.; Yurkov, A.M.; Rillig, M.C. Tradeoffs in hyphal traits determine mycelium architecture in saprobic fungi. Sci. Rep. 2019, 9, 14152. [Google Scholar] [CrossRef] [PubMed]
- Pasailiuk, M.V.; Sukhomlyn, M.; Gryganskyi, A.P. Patterns of Hericium coralloides growth with competitive fungi. Czech Mycol. 2019, 71, 49–63. [Google Scholar] [CrossRef]
- Jahedi, A.; Ahmadifar, S.; Mohammadigoltapeh, E. Revival of wild edible-medicinal mushroom (Hericium erinaceus) based on organic agro-industrial waste- achieving a commercial protocol with the highest yield; optimum reuse of organic waste. Sci. Hortic. 2024, 323, 112510. [Google Scholar] [CrossRef]
- Guadarrama-Mendoza, P.C.; Toro, G.V.; Ramírez-Carrillo, R.; Robles-Martínez, F.; Yáñez-Fernández, J.; Garín-Aguilar, M.E.; Hernández, C.; Bravo-Villa, G. Morphology and mycelial growth rate of Pleurotus spp. strains from the Mexican mixtec region. Braz. J. Microbiol. 2014, 45, 861–872. [Google Scholar] [CrossRef] [PubMed]
- Gerbec, B.; Gregori, A.; Kreft, S.; Berovič, M. Solid state cultivation of Hericium erinaceus biomass and erinacine: A production. J. Bioprocess. Biotech. 2015, 5, 1–5. [Google Scholar]
- Chang, C.H.; Chen, Y.; Yew, X.X.; Chen, H.X.; Kim, J.X.; Chang, C.C.; Peng, C.C.; Peng, R.Y. Improvement of erinacine A productivity in Hericium erinaceus mycelia and its neuroprotective bioactivity against the glutamate-insulted apoptosis. LWT 2016, 65, 1100–1108. [Google Scholar] [CrossRef]
- Dong, Y.; Miao, R.; Feng, R.; Wang, T.; Yan, J.; Zhao, X.; Han, X.; Gan, Y.; Lin, J.; Li, Y.; et al. Edible and medicinal fungi breeding techniques, a review: Current status and future prospects. Curr. Res. Food Sci. 2022, 5, 2070–2080. [Google Scholar] [CrossRef]
- Singh, R.; Sharma, S. Evaluation, maintenance, and conservation of germplasm. Adv. Bot. Res. 2007, 45, 465–481. [Google Scholar]
- Largeteau, M.L.; Baars, J.J.; Juarez del Carmen, S.; Regnault-Roger, C.; Savoie, J.M. Wild strains of Agaricus bisporus: A source of tolerance to dry bubble disease. In Proceedings of the Genetics and Cellular Biology of Basidiomycetes VI; Pisabarro, A.G., Ramirez, L., Eds.; Universidad Publica de Navarra: Pamplona, Spain, 2005; pp. 77–87. [Google Scholar]
- Gong, W.B.; Xu, R.; Xiao, Y.; Zhou, Y.; Bian, Y.B. Phenotypic evaluation and analysis of important agronomic traits in the hybrid and natural populations of Lentinula edodes. Sci. Hortic. 2014, 179, 271–276. [Google Scholar] [CrossRef]
- Gong, W.B.; Xie, C.L.; Zhou, Y.J.; Zhu, Z.H.; Wang, Y.H.; Peng, Y.D. A resequencing-based ultradense genetic map of Hericium erinaceus for anchoring genome sequences and identifying genetic loci associated with monokaryon growth. Front. Microbiol. 2020, 10, 3129. [Google Scholar] [CrossRef] [PubMed]
- Han, L.; Parekh, S.R. Development of improved strains and optimization of fermentation processes. In Microbial Processes and Products; Barredo, J.L., Ed.; Methods in Biotechnology; Humana Press: Totowa, NJ, USA, 2005; Volume 18. [Google Scholar]
- Dai, X.; Zhang, J.; Han, Z.; Zhan, Y.; Wang, Y. Growth parameters and ergosterol content of mycelia and fruit bodies of ten Hericium erinaceus strains collected from the wild in Heilongjiang Province, China. Acta Edulis Fungi 2014, 21, 45–49. [Google Scholar]

| No. | n-Hexane | Ethyl Acetate | Methanol | Water | K Value |
|---|---|---|---|---|---|
| 1 | 3 | 5 | 3 | 5 | 4.84 |
| 2 | 4 | 5 | 4 | 5 | 1.19 |
| 3 | 4.5 | 5 | 4.5 | 5 | 0.81 |
| 4 | 5 | 5 | 5 | 5 | 0.51 |
| Strain | Type | Origin | Mycelial Growth Rate (mm/d) | Mycelial Biomass (g/L) | Erinacine A Content (mg/g) | Erinacine A Yield (mg/L) |
|---|---|---|---|---|---|---|
| He1 | Cultivar | Sichuan | 4.31 ± 0.173 | 9.76 | 0.34 ± 0.004 | 3.31 ± 0.040 |
| He911 | Cultivar | Jiangsu | 3.33 ± 0.016 | 7.03 | 1.89 ± 0.005 | 13.28 ± 0.035 |
| HeCS | Cultivar | Changshan, Zhejiang | 3.94 ± 0.168 | 9.52 | 0.44 ± 0.004 | 4.22 ± 0.038 |
| HeJ | Cultivar | Sichuan | 3.81 ± 0.382 | 9.23 | 0.23 ± 0.013 | 2.09 ± 0.121 |
| HeC95 | Hybrid strain | CS-5*911-4 | 3.57 ± 0.067 | 10.57 | 2.10 ± 0.007 | 22.23 ± 0.079 |
| HeC9 | Hybrid strain | CS-4*911-4 | 3.03 ± 0.242 | 6.99 | 21.15 ± 0.098 | 147.87 ± 0.686 |
| He92 | Hybrid strain | Lishui, Zhejiang | 2.10 ± 0.034 | 6.00 | 0.30 ± 0.002 | 1.77 ± 0.010 |
| He34 | Wild strain | Wangqing County, Jilin | 2.18 ± 0.099 | 9.66 | 0.29 ± 0.001 | 2.77 ± 0.014 |
| He80 | Wild strain | Khingan Mountains, Heilongjiang | 3.43 ± 0.100 | 8.45 | 3.66 ± 0.015 | 30.92 ± 0.125 |
| He89 | Wild strain | Dongning County, Jilin | 3.29 ± 0.089 | 7.93 | 0.38 ± 0.005 | 3.04 ± 0.041 |
| HeG | Wild strain | Jiaohe, Jilin | 2.27 ± 0.185 | 8.51 | 42.16 ± 0.181 | 358.78 ± 1.537 |
| HeR | Wild strain | Yichun, Heilongjiang | 2.89 ± 0.096 | 8.79 | 0.60 ± 0.002 | 5.26 ± 0.020 |
| HeT | Wild strain | Yichun, Heilongjiang | 3.03 ± 0.195 | 9.70 | 4.07 ± 0.024 | 39.47 ± 0.238 |
| HeU | Wild strain | Yichun, Heilongjiang | 3.42 ± 0.227 | 7.69 | 0.50 ± 0.014 | 3.88 ± 0.107 |
| HeV | Wild strain | Yichun, Heilongjiang | 2.30 ± 0.159 | 7.21 | 0.33 ± 0.001 | 2.38 ± 0.008 |
| He61 # | Wild strain | Khingan Mountains, Heilongjiang | 2.12 ± 0.109 | 11.99 | 0.30 ± 0.001 | 3.60 ± 0.006 |
| He114 # | Wild strain | Khingan Mountains, Heilongjiang | 2.49 ± 0.155 | 8.28 | 0.39 ± 0.001 | 3.20 ± 0.003 |
| Source of Variation | Sum of Squares | Degree of Freedom | Mean Squares | F Value | p Value | |
|---|---|---|---|---|---|---|
| Erinacine A content | Between groups | 5688.739 | 16 | 355.546 | 138,662.199 | <0.001 |
| Within groups | 0.087 | 34 | 0.003 | |||
| Total | 5688.826 | 50 | ||||
| Erinacine A yield | Between groups | 387,580.136 | 16 | 24,223.759 | 139,967.804 | <0.001 |
| Within groups | 5.884 | 34 | 0.173 | |||
| Total | 387,586.021 | 50 |
Disclaimer/Publisher’s Note: The statements, opinions and data contained in all publications are solely those of the individual author(s) and contributor(s) and not of MDPI and/or the editor(s). MDPI and/or the editor(s) disclaim responsibility for any injury to people or property resulting from any ideas, methods, instructions or products referred to in the content. |
© 2024 by the authors. Licensee MDPI, Basel, Switzerland. This article is an open access article distributed under the terms and conditions of the Creative Commons Attribution (CC BY) license (https://creativecommons.org/licenses/by/4.0/).
Share and Cite
Liu, M.; Liu, L.; Song, X.; Zhou, Y.; Peng, Y.; Xie, C.; Gong, W. Isolation and Evaluation of Erinacine A Contents in Mycelia of Hericium erinaceus Strains. Foods 2024, 13, 1649. https://doi.org/10.3390/foods13111649
Liu M, Liu L, Song X, Zhou Y, Peng Y, Xie C, Gong W. Isolation and Evaluation of Erinacine A Contents in Mycelia of Hericium erinaceus Strains. Foods. 2024; 13(11):1649. https://doi.org/10.3390/foods13111649
Chicago/Turabian StyleLiu, Mengchen, Liangliang Liu, Xiaoya Song, Yingjun Zhou, Yuande Peng, Chunliang Xie, and Wenbing Gong. 2024. "Isolation and Evaluation of Erinacine A Contents in Mycelia of Hericium erinaceus Strains" Foods 13, no. 11: 1649. https://doi.org/10.3390/foods13111649
APA StyleLiu, M., Liu, L., Song, X., Zhou, Y., Peng, Y., Xie, C., & Gong, W. (2024). Isolation and Evaluation of Erinacine A Contents in Mycelia of Hericium erinaceus Strains. Foods, 13(11), 1649. https://doi.org/10.3390/foods13111649

